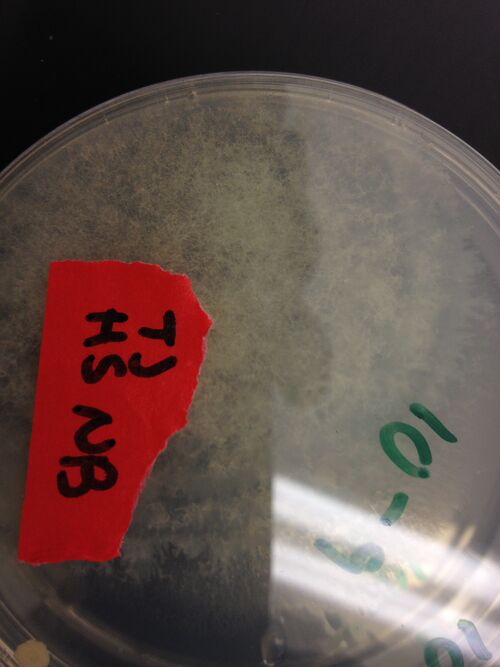

User:Nicole Bonan/Notebook/Biology 210 at AU
Comparison of Bacteria from Transect 5 with Other Sequenced Bacterial DNA from Transect 5
Nicole Bonan
TA: Alyssa Pedersen
Lab Section: D01
July 21, 2014
Introduction
Massilia aurea and Janthinobacterium lividum are both bacteria that can be found in soils. In 2006, Massilia aura was isolated from drinking water in Seville, Spain. It is a relatively novel type of bacteria, so little has been published about it. Massilia aurea are gram-negative bacteria that form yellow, circular colonies1. Janthinobacterium lividm are gram negative bacteria that form purple-black, rod-shaped colonies. In addition to being found in the soil, they can also exist in spoiled milk. Janthinobacterium lividum can, in rare cases, cause septicemia in humans2, which is a life-threatening reaction to bacterial infections in the body. The death rate for some septicemia infections can be as high as 50%3. However, this bacteria also creates the pigment violacein, which causes its purple color. Violacein is toxic to bacteria, viruses, protozoa, and fungi. Janthinobacterium lividum also creates three other antibiotics that are effective against both gram negative and gram positive bacteria, and it is resistant to ß-lactam antibiotics2.
The purpose of this lab was to identify the bacteria isolated from the soil sample from Transect 5 based on their DNA sequence. However, since the polymerase chain reaction (PCR) sequencing of the 16s gene from the bacteria was not successful, DNA sequences from Transect 5 bacteria collected by previous lab sections were used. The materials and methods, results, tables and graphs, and discussion of this experiment will be discussed in the following sections.
Materials and Methods
After receiving the DNA sequences of the bacteria from previous labs, the National Center for Biotechnology Information's (NCBI) Basic Local Alignment Search Tool (BLAST) was used to identify two bacteria based on their DNA sequence. Each DNA sequence was pasted into the Standard Nucleotide BLAST's query, and the bacterium that most closely matched the DNA sequence was identified. After that, the bacteria were researched in order to qualitatively compare them to the bacteria that were observed from Transect 5.
Results
The first bacterium that was identified using NCBI's BLAST was Massilia aura. This bacterium was motile and rod-shaped. It was about 1.0µm in width by 1.6µm in length, and it was gram negative. Colonies of <Massilia aura were yellow in color and were circular. They were between 0.6 and 1.0µm in diameter. In contrast, the first bacterium observed in Transect 5 was not motile and was circular with a few longer, skinny strands. Its colonies had an irregular shape, curled margins, and a convex elevation. However, the bacterium was gram negative, and its colonies were yellow, like the Massilia aura.
The second bacterium that was identified using NCBI's BLAST was Janthinobacterium lividum. This bacterium was violet in color and rod-shaped, and it was gram negative. Its colonies were purple-black in color and were rod-shaped. In contrast, the second bacterium that was observed from Transect 5 was not motile, had a sponge-like consistency, was black-gold-brown in color, and had what appeared to be an antenna. It was also gram positive, and its colony was part of a lawn on the agar plate.
Tables and Graphs
Table 1: Comparison of First Bacterium Observed from Transect 5 with Massilia aura

Table 2: Comparison of Second Bacterium Observed from Transect 5 with Janthinobacterium lividum

Discussion
The bacteria Massilia aurea and Janthinobacterium lividum can both be found in soils. Massilia aurea are gram-negative bacteria that form yellow, circular colonies1. Janthinobacterium lividum are gram negative bacteria that form purple-black, rod-shaped colonies. This bacteria creates the pigment violacein, which is responsible for the bacteria's purple color. Violacein is toxic to bacteria, viruses, protozoa, and fungi. Janthinobacterium lividum also creates three other antibiotics that are effective against both gram negative and gram positive bacteria, and it is resistant to ß-lactam antibiotics2.
The purpose of this experiment was to identify two bacteria from Transect 5 using NCBI's BLAST and to qualitatively compare these bacteria with two of the bacteria isolated from Transect 5. The two bacteria identified were Massilia aura and Janthinobacterium lividum, and while the Massilia aura had a few characteristics that were similar to one of the bacteria observed from Transect 5, neither of the identified bacteria seemed to be the bacteria that were observed.
Of course, there were sources of error in this experiment. One source of error was that the DNA sequences used were from bacteria that were sampled from Transect 5 in a different season than the bacteria were observed. Different bacteria may exist in the soil at different points in the year, so the bacteria might not have matched for this reason. A way that this error could be minimized would be to run the experiment again so that DNA samples from the bacteria that were observed could be used. Another source of error was that the results of the PCR were sent to a separate lab. The transportation could have damaged the samples in some way, causing them to be unusable. A way that this could be minimized would be to send multiple samples of the product of the PCR from the same bacteria. A final source of error was that the wrong bacteria might have been selected from the BLAST list of bacteria that closely matched the DNA. There might have been other bacteria that more closely matched the bacteria observed, but their DNA did not match the DNA sequence that was entered into the BLAST as closely. A way to minimize this error would have been to go through all of the bacteria whose DNA was similar to the one entered into the BLAST and try to find the ones that most closely matched the bacteria that were observed.
The results of this experiment make sense for Transect 5. Both the bacteria that were identified using NCBI's BLAST, Massilia aura and Janthinobacteria lividum, are present in soils and damp areas, such as Transect 5. They were also similar in appearance to the bacteria that were observed from Transect 5, indicating that they might be from the same family of bacteria.
The results of this experiment have multiple implications. Many types of bacteria can be found in soils, and these bacteria can be both harmful and helpful to humans. For example, the Janthinobacterium lividum can cause serious illnesses in humans, but it can also create antibiotics. These antibiotics can be studied to create new treatments for bacterial infections in humans. Also, the fact that Massilia aura was found in drinking water would make it an interesting and important bacteria to study further. The impact of this bacteria on human health should be researched in order to determine if this bacteria should be prevented from being in drinking water.
References
1Gallego, V; Sánchez-Porro, C; García, MT; Ventosa, A. “Massilia aurea sp. nov., isolated from drinking water”. 2006. International Journal of Systematic and Evolutionary Microbiology. (2014 Jul 25) http://ijs.sgmjournals.org/content/56/10/2449.full
2Tabor-Godwin, J; Stuart, R; Zayas, RIL; Rajakuberan, C. “What you didn’t know about janthinobacterium”. 2009. American Society for Microbiology. (2014 Jul 25). http://schaechter.asmblog.org/schaechter/2009/04/by-jenna-tabor-godwin-rhona-stuart-rosa-i-león-zayas-and-chitra-rajakuberan--------janthinobacterium-cultured-on-nb-aga.html
3Vorvick, L; Vyas, JM; Zieve, D. “Septicemia”. MedlinePlus. 2014. United States National Library of Medicine, National Institutes of Health. (2014 Jul 27). http://www.nlm.nih.gov/medlineplus/ency/article/001355.htm
Lab 5: Invertebrates
Nicole Bonan
TA: Alyssa Pedersen
Lab Section: D01
July 14, 2014
Introduction
95% of animals are invertebrates, and there are more than a million identified species of invertebrates7. Invertebrates can be separated into two groups based on how their embryos develop1. Protosomes' mouths develop from the blastophore, which is the first opening into the gut, and their coelom, or body cavity, creates a gap in the mesoderm11. In contrast, deuterosomes' mouths form from a gut opening other than the blastophore. Buds on the gut eventually develop into their coelom10. Arthropods, which include most of the insects in soil, are a type of protosome. This phylum includes myriapods, trilobites, chelicerates, crustaceans, and insects, and most of the species in this phylum have bilateral symmetry, a segmented body, jointed legs, multiple pairs of limbs, and a hard exoskeleton13. Arthropods also have all three types of germ tissue: the ectoderm, which creates the skin and nervous system; the endoderm, which creates the digestive tract's lining; and the mesoderm, which creates the organs, bones, muscle, and circulatory system1.
The purpose of this lab was to observe invertebrates and to identify four samples of invertebrates caught in the Berlese funnel from the last lab. It was hypothesized that if there were invertebrates in the Berlese funnel, then these invertebrates would likely feed on small organisms in the soil or decomposing plant matter. This hypothesis was made because most of the leaf litter that was put in the Berlese funnel contained decomposing plant matter, so it was likely that the diet of organisms found in the litter would be rich in these substances. In the following report, the methods used, results, data, and interpretation of the results of the experiment will be discussed.
Materials and Methods
In the first part of the lab, acoelmates, pseudocoelmates, and coelmates were observed under dissecting microscopes. The acoelmate observed was a cross-section of Planaria, the pseudoacoelmate observed was a sample of live nematodes, and the coelmate observed was a cross section of Annelida.
In the second part of the lab, organisms from each of the five major classes of arthropods were observed under a microscope. The five major classes were arachnida, diplopoda, chilopoda, insect, and crustacea.
In the third part of the lab, organisms that were captured in the Berlese funnel were observed and identified. The solution inside of the funnel system's test tube was poured out into two separate petri dishes, and from the petri dishes, organisms were pipetted onto wet mount slides using a disposable pipette. The slides were then observed under a dissecting microscope, and the organisms were identified using a dichotomous key.
Results
The nematodes observed in the first part of the procedure were able to wiggle back and forth, but they were not able to move in a specific direction. There were many nematodes in the sample, and each looked like thin, colorless tubes. Inside the tubes were the nematodes' digestive tract, which appeared as small black specks.
Three organisms were identified from Transect 5 and one from Transect 1 in the Berlese funnel. The organisms identified were a sucking louse, a biting louse, a fly, and what appeared to be a caterpillar but was identified by the dichotomous key as a termite. The sucking louse was the smallest organism identified; it was 0.100mm in diameter. This organism had radial symmetry and looked like a colorless octopus with two sets of tentacles. The biting louse was It was 0.120mm in length. It was covered in small hairs and had a stinger, pair of antennae, and many legs. The fly was the largest organism identified; it was 6.75mm in length. The fly was gold-brown in color and had one set of wings, feelers, antennae, and many legs. The termite/caterpillar was 5.00mm in length. It had many pairs of legs and a bumpy, knobby body. The size range of the organisms was from 0.100mm to 6.75mm. Both the sucking and biting lice seemed to be the most common in the leaf litter.
Tables and Graphs
Table 1: Organisms Collected via Berlese Funnel

Figure 1: Sketch of Sucking Louse

Figure 2: Sketch of Biting Louse

Figure 3: Sketch of Fly

Figure 4: Sketch of Termite/Caterpillar

Figure 5: Final Summary Figure: Food Web of All Organisms Identified in Transect 5

Discussion
95% of animals are invertebrates, and there are more than a million identified species of invertebrates7. Invertebrates can be separated into two groups, protosomes and deuterosomes, based on how their embryos develop1. Arthropods, which include most of the insects in soil, are a type of protosome. Most arthropods have bilateral symmetry, a segmented body, jointed legs, multiple pairs of limbs, and a hard exoskeleton13. Arthropods also have all three types of germ tissue: ectoderm, endoderm, and mesoderm1.
The purpose of this lab was to identify four samples of invertebrates caught in the Berlese funnel from the last lab. It was hypothesized that if there were invertebrates in the Berlese funnel, then these invertebrates would likely feed on small organisms in the soil or decomposing plant matter. This hypothesis was made because most of the leaf litter that was put in the Berlese funnel contained decomposing plant matter, so it was likely that the diet of organisms found in the litter would be rich in these substances. However, the results did not completely support the hypothesis. The organisms identified from Transect 5 were a sucking louse, a biting louse, and a fly; while flies do consume some decomposing plant matter12, the lice do not. Sucking lice are parasites and consume blood from their host. Biting lice are ectoparasites and consume parts of feathers, hair, skin, and blood from their host. Biting lice are especially present on birds, however9, and there were a number of birds observed in the transect.
Five vertebrates that were likely to have inhabited Transect 5 are the American toad, Northern cardinal, American crow, Red squirrel, and the Eastern chipmunk. These vertebrates will be described in the following five paragraphs.
The phylum, class, order, family, genus, and species of the American toad are Chordata, Amphibia, Anura, Bufonidae, Bufo, and Bufo americanus, respectively. The toads tend to live in moist areas so that they can obtain oxygen and water through their skin and so that they can reproduce. The presence of the drainage ditch in Transect 5, which would provide the toads with water, is an abiotic factor that would be beneficial to the toads. Toads also eat insects and small invertebrates, which are common in the transect; these biotic factors would thus be beneficial to the toads as well2.
The phylum, class, order, family, genus, and species of the Northern cardinal are Chordata, Aves, Passeriformes, Cardinale, Cardinalis, and Cardinalis cardinals, respectively. Seeds and insects are a part of their diet; both of these biotic factors are likely to be found in Transect 5, which would benefit the cardinal. Cardinals also create nests in small trees, of which there are two in the transect. These trees would also be beneficial for providing a place to nest for the birds5.
The phylum, subphylum, class, order, family, genus, and species of the American crow are Chordata, Vertebrata, Aves, Passeriformes, Corvidae, Corvus, and Corvus brachyrhynchos, respectively. Crows are commonly found in urban parks, which have a similar environment to Transect 5. They also consume a wide variety of food, including seeds, insects, worms, and small mammals such as frogs. These organisms are all likely to be found in the transect, so these biotic factors would benefit the crow. Crows also keep food in caches for short-term storage. They create caches in places like crevices in trees or covered in leaves on the ground. Both the trees and the leaf litter in the transect are factors that would be beneficial to the crow, as they would provide places where the crows can store food6.
The phylum, subphylum, class, order, family, genus, and species of the Red squirrel are Chordata, Vertebrata, Mammalia, Rodentia, Sciuridae, Tamiasciurus, and Tamiascurus hudsonicus, respectively. Red squirrels live in both forest and urban settings, so the mix of biotic plant life in Transect 5 and the abiotic surrounding urban landscape, such as dorm buildings, sidewalks, and drainage systems, would benefit the squirrels. Squirrels consume seeds, flowers, tree sap, bark, and insects, to name a few things. All of these foods would be found in Transect 5, so these biotic factors would benefit the squirrels8.
The phylum, subphylum, class, order, family, genus, and species of the Eastern chipmunk are Chordata, Vertebrata, Mammalia, Rodentia, Sciuridae, Tamias, and Tamias striates, respectively. Chipmunks eat a variety of foods, including insects, earthworms, mushrooms, and seeds. These biotic factors would likely be found in Transect 5, and would benefit the species. Chipmunks also create burrows to live in, and they find shelter under things like tree stumps and rocks. The abundance of rocks in Transect 5 would also benefit the chipmunks by offering them potential shelter4.
According to Freeman's Biological Science: Fifth Edition, a community consists of all of the species in a certain area that interact with each other. The food web diagrammed in Figure 5 shows the nutritional relationship between all of the identified organisms in Transect 5, in terms of what organism eats what. All of these organisms interacted with each other within the transect by consuming other organisms, so they represented a community. A trophic level is defined by Freeman as a feeding level in an ecosystem. The organisms from Transect 5 represented this concept: organisms such as plants and trees represented the bottom feeding level; microorganisms such as the amoeba represented the next feeding level; insects represented the third feeding level; smaller mammals, such as the American toad, represented the fourth feeding level; and larger mammals, such as the birds, represented the fifth feeding level. Generally, the higher the trophic level, the more organisms must have been consumed (e.g., an amoeba, which represents a lower trophic level, consumes decaying organic matter. A Northern cardinal, which represents a higher trophic level, consumes an American toad, which consumes a fly, which consumes a gnat, which consumes the decaying plant matter). A carrying capacity is defined by Freeman as the largest size of a population of species that a specific habitat can support. The organisms in Transect 5 represented this concept as well. For example, there were fewer birds than microorganisms or plants in the transect. This difference in population size between species existed because there was an abundance of nutrients available to the plants and microorganisms, such as light and decomposing plant matter, respectively, while the nutrients available to the birds was more limited3.
Of course, there were sources of error in this experiment. One source of error was that the dichotomous key used to identify organisms might not have been inclusive enough. As a result, some organisms might have been misidentified. A way that this error could have been reduced would be to use a larger dichotomous key that can identify more organisms. Another source of error was that because the Berlese funnel was not a closed system, some organisms in the lab could have entered the funnel and been identified as organisms from the transect. A way to reduce this error would have been to close the entire funnel system in a container that would not let organisms into the system. A third source of error was that the leaf litter sample was collected without using gloves, so it could be possible that the sample was contaminated by some organisms that were not from the transect, or that were from human skin. A way to reduce this error would have been to use gloves when collecting the leaf litter sample.
The results of this experiment could be applied to the study of climate change to observe its effect on relationships among organisms. For example, if the increase in greenhouse gas emissions is causing global temperatures to rise, certain plants may not be able to grow in habitats that they would previously thrive in. This would cause a lack of food for the organisms that consume those plants, which could effect organisms all the way up to the top of the food chain. Or, climate change could allow plants to grow in areas that would have normally been uninhabitable to them. This change might create new food sources for organisms, which might encourage invasions of non-native species. These types of effects on the environment could be determined by studying the relationships among organisms in an ecosystem.
References
1Bentley; Walters-Conte; Zeller. 2014. Bio 210 Lab Manual. AU Campus Store: Washington, DC. 39-44.
2Francisco, Mackenzie. “American Toad (Bufo Americans). American Toad (Bufo Americans). April 23, 2010. The University of Wisconsin: La Crosse. (16 Jul 2014) <http://bioweb.uwlax.edu/bio203/2010/francisc_mack/classification.htm>
3Freeman, Scott, et. al. 2014. Biological Science: Fifth Edition. Pearson: Boston. G:5; G:8; G:37.
4Kroll, M. “Tamias striatus”. Animal Diversity Web. 2013. The University of Michigan Museum of Zoology. (16 Jul 2014) <http://animaldiversity.ummz.umich.edu/accounts/Tamias_striatus/>
5New Hampshire Public Television. “Northern Cardinal – Cardinalis cardinalis”. Nature Works. 2014. New Hampshire Public Television. (16 Jul 2014) <http://www.nhptv.org/natureworks/cardinal.htm>
6Parr, C. “Corvus brachyrhynchos”. Animal Diversity Web. 2005. The University of Michigan Museum of Zoology. (16 Jul 2014) <http://animaldiversity.ummz.umich.edu/accounts/Corvus_brachyrhynchos/>
7Pedersen, Alyssa. (2014 Jul 14). Lab 5 Lecture. Bio 210 Lab 5. Lecture conducted from American University, Washington, DC
8Rubin, C. “Tamiasciurus hudsonicas”. Animal Diversity Web. 2012. The University of Michigan Museum of Zoology. (16 Jul 2014) <http://animaldiversity.ummz.umich.edu/accounts/Tamiasciurus_hudsonicus/>
9The Amateur Entomologists’ Society. “Biting and Sucking Lice (Order: Phthiraptera)”. Insects. 2014. The Amateur Entomologists’ Society. (16 Jul 2014) <http://www.amentsoc.org/insects/fact-files/orders/phthiraptera.html>
10The Editors of Encyclopedia Britannica. “Deuterostomia”. Encyclopedia Britannica. July 20, 2012. Encyclopedia Britannica, Inc. (15 Jul 2014) <http://www.britannica.com/EBchecked/topic/159746/Deuterostomia>
11The Editors of Encyclopedia Britannica. “Protosoma”. Encyclopedia Britannica. July 20, 2012. Encyclopedia Britannica, Inc. (15 Jul 2014) <http://www.britannica.com/EBchecked/topic/480466/Protostomia>
12The University of Arizona Center for Insect Science Education Outreach. “Fly Information”. Using Live Insects in Elementary Classrooms: For Early Lessons in Life. 1997. The University of Arizona. (16 Jul 2014) <http://insected.arizona.edu/flyinfo.htm>
13Understanding Evolution. “The Arthropod Story”. Understanding Evolution. 2004. The University of California Museum of Paleontology; The National Center for Science; The National Science Foundation; The Howard Hughes Medical Institute. (15 Jul 2014) <http://evolution.berkeley.edu/evolibrary/article/_0_0/arthropods_03>
Lab 4: Plantae and Fungi
Nicole Bonan
TA: Alyssa Pedersen
Lab Section: D01
July 9, 2014
Introduction
Plants evolved from green algae about 450 million years ago (MYA)1, when space and resources in aquatic environments was becoming scarce for much of the algae3. While both the plants and algae were eukaryotic, photosynthetic, and had chloroplasts, the plants differed from the algae in that the plants were multicellular and could develop embryos1. These early plants were similar to today's phyla of bryophytes, which are non-vascular plants such as moss. About 50 million years later, in the Devonian period, part of the bryophyte phyla evolved into tracheophtyes, which were plants that had a vascular system. About 360 MYA, some tracheophytes evolved and eventually had the ability to produce seeds. Gymnosperms are an example of a group of this type of plant. This development was another major branch in the evolution of plants. Finally, in the Cretaceous period about 130 MYA, angiosperms evolved: these types of platens could flower and reproduce by spreading pollen, which continued their gametes, through the air. Thus, these plants were able to inhabit many more parts of their environment3.
The purpose of this experiment was to observe five plants from Transect 5; observe and learn about the vascularization, cell specialization, and reproduction of plants; observe fungi; and to set up a Berlese Funnel to collect invertebrates in a leaf litter sample from Transect 5. In the following report, the materials and methods, results, and discussion of the experiment will be covered.
Materials and Methods
In the first part of this lab, leaf samples, a leaf litter sample, and flower samples were taken from Transect 5 and observed. In the second part of the lab, mnium moss was observed under a compound microscope, and a cross section of a lily stem was observed under a dissecting microscope in order to compare their vascularization. In the third part of the lab, mnium moss was again observed under a compound microscope, and a cross-section of an angiosperm was observed under a dissecting microscope. The shape, size, and cluster arrangement of the leaves was compared. In the fourth part of the lab, male and female mosses were observed under a microscope, and an angiosperm and also monocot and dicot seeds were dissected. The reproductive structures of these specimens were observed, as were the reproductive structures of the two flower samples that were brought back from Transect 5. In the fifth part of the lab, the fungi Rhizopus stolonifer and <Rhizopus zigospoers were observed under compound microscopes, and notes about the samples were taken. In the final part of the lab, the Berlese funnel was set up to catch any invertebrates that might have been in the leaf litter sample from Transect 5. The Berlese funnel consisted of a plastic funnel that led into a test tube filled with 25mL 75% ethanol solution. The joint between the funnel and test tube was covered in Parafilm so that the ethanol would not evaporate. A screen was taped with labeling tape to the inside of the funnel to prevent large debris from passing into the test tube. Both the funnel and the test tube were clamped to a ring stand. The leaf litter samples was placed in the funnel, the Berlese funnel was placed under a light, and the entire light/funnel apparatus was covered in aluminum foil and allowed to sit until the next lab.
Results
The five leaf samples taken from Transect 5 were determined to be: an angiosperm from the asclepias genera; a gymnosperm fem the swida genera5; an angiosperm from the lagerstroemia genera8; a gymnosperm from the buxus genera2; and a gymnosperm from the liripoe genera7.
The leaf from the asclepias had a network of branched veins. Medium-sized veins made loops back to the main vein, and smaller, tree branch-like veins ran throughout the leaf. The shape of the leaf was long, narrow, and curved, like a flame. Its margin was entire3. Its size was 5.86mm in length by 1.40mm in width. The leaves on the asclepias were opposite each other in clusters of two.
The leaf from the swida had a network of veins branching out from a single main vein. Smaller veins connected the medium-sized ones. The shape of the leaf was broad and teardrop-shaped, and its margin was entire6. Its size was 11.15mm long by 5.10mm wide. The leaves on the swida were opposite each other in clusters of two, except for the leaves near the end of the branches. These leaves were in clusters of three or more.
The leaf from the lagerstroemia had a network of branched veins. Medium veins made loops back to the main vein, but not as clearly as in the asclepias. The shape of the leaf was rounded and teardrop-shaped, and its margin was entire6. Its size was 6.15mm long by 3.90mm wide. The leaves on the leagerstroemia were in clusters of about four.
The leaf from the buxus had a network of branched, light green veins. These veins were very small and narrow. The shape of the leaf was symmetrical; the leaf had three bumps toward the end of the leaf. The leaf margin was crenate6, and its size was 3.35mm long by 1.00mm wide.
The leaf from the liriope had long, parallel veins that ran the length of the leaf. The shape of the leaf was long and narrow, and the end of the leaf was pointed. The leaf margin was entire6, and the size of the leaf was 46.00mm long by 0.75mm wide.
In part 4 of the lab, plant reproduction was studied. While no seeds were collected from Transect 5, two flower samples were collected. Both of the flowers were identified as dicot, as they flowered in multiples of five.
In part 5 of the lab, fungi were studied. A sample of Rhizopus stolonifer was observed in a petri dish under a dissecting microscope. This sample was a fungus from the zygomycota group. Small black spots existed throughout the sample, which were identified as sporangia. White fibers called hyphae filaments criss-crossed the sample, often dead-ending into the sporangia. On the other side of the petri dish, small filaments that looked similar to roots were observed. These were identified as rhizoids. A sample of Rhizopus zigospores was also observed in a separate slide under a dissecting microscope. This sample was a fungus from the zygomycota group as well, and it consisted of what looked like fuchsia-colored tadpoles. The "head" of the tadpole was very dark fuchsia, while the "body" was a lighter shade of fuchsia and eventually trailed off into a thin, long filament. Many of these structures were clustered together on the bottom left of the slide, and the pink filaments crisscrossed much of the slide.
Tables and Graphs
Table 1: Information about Plants #1-5 in Transect 5

Figure 1: Image of Plant #1

Figure 2: Image of Plant #2

Figure 3: Image of Plant #3

Figure 4: Image of Plant #4

Figure 5: Image of Plant #5

Figure 6: Image of All Five Leaf Samples

Figure 7: Image of Leaf Litter Location

Figure 8: Image of Flower Samples from Transect 5

Figure 9: Sketch of Rhizopus stolonifer as Observed Under Microscope

Figure 10: Sketch of Rhizopus zigospres as Observed Under Microscope

Discussion
Plants evolved from green algae about 450 million years ago (MYA)1. These early plants were similar to today's phyla of bryophytes, which are non-vascular plants such as moss. About 50 million years later, in the Devonian period, part of the bryophyte phyla evolved into tracheophtyes, which were plants that had a vascular system. Other major developments in the evolution of plants enabled some types of plants to produce seeds, and then to flower3, which helped to increase the diversity of plant life as we know it today.
The purpose of this experiment was to observe five plants from Transect 5; learn about the vascularization, cell specialization, and reproduction of plants; observe fungi; and to set up a Berlese Funnel to collect invertebrates in a leaf litter sample from Transect 5. The results of this experiment were that one monocot and four dicot plant species were observed in the transect, and notes about their vascularization, size, shape, and cluster arrangement were taken. Fungi samples were also observed in the lab.
Fungi sporangia are important in the reproduction of fungi. Sporangia are structures that produce spores asexually4; these spores are released into the air when the sporangia open3. In this way, the spores can spread and grow into new fungi. The sample that was observed in the lab, Rhizopus stolonifer, was fungus. This specimen had visible sporangia, which looked like small black dots evenly spread throughout the fungus. The presence of hyphae filaments was another indicator that this specimen was a fungus. Some of these filaments grew together to form the sporangia.
Of course, there were sources of error in this experiment. One source of error was that the plants in Transect 5 were not naturally-occurring, so the plants may not have been representative of native species in the area. A way that this could have been minimized would have been to have taken leaf samples from weeds in the transect. However, because the area is heavily landscaped, the leaf samples that were taken could be representative of plants that are appealing to humans, which was one of the goals of landscaping that area. Another source of error was that gloves were not used when collecting leaf litter samples, so the sample could be contaminated by microorganisms from human skin. A way that this error could be minimized would be to use gloves when collecting the leaf litter samples. A third source of error was that the leaf litter sample was not taken from near the five observed plants in the transect, as there was no leaf litter in those areas. A way that this error could have been minimized would have been to come back in the fall and take leaf litter samples when it would be more likely that leaves would have fallen off of those plants.
The results of this experiment could be used to help identify plants and also to help better understand the phylogenetic tree of different plant species. By observing differences in the vascular system or reproductive process of plants, as well as by observing many different fossils of earlier species of plants, phylogenetic trees can be created with more data about the similarities and differences that exist between plant types. These differences could also be used to make more specific dichotomous keys, which could be used to more accurately identify plant species.
References
1Abedon, Stephen T. “Supplemental Lecture”. The Bacteriophage Ecology Group. May 5, 1997. The Ohio State University: Mansfield. (Jul 14, 2014) <http://www.mansfield.ohio-state.edu/~sabedon/biol3060.htm>
2American Boxwood Society. “About Boxwood”. About Boxwood. American Boxwood Society. (Jul 14, 2014) <http://www.boxwoodsociety.org/about_boxwood.htm>
3Bentley; Walters-Conte; Zeller. 2014. Bio 210 Lab Manual. AU Campus Store: Washington, DC. 26-37.
4Council-Garcia, Cara Lee. “Fungi”. Biology 203L. 2002. The University of New Mexico. (July 13, 2014). <http://biology.unm.edu/ccouncil/Biology_203/Summaries/Fungi.htm>
5New England Wild Flower Society. "Full Key for Plant Identification: Go Botany". Go Botany. 2013. New England Wild Flower Society. (11 Jul. 2014) <https://gobotany.newenglandwild.org/full/>
6Northwest Missouri State University. “Leaf Margins”. Leaf Identification. 2008. Northwest Missouri State University. (July 12, 2014). <http://cite.nwmissouri.edu/nworc/files/agriculture/leafid_margin/leafid_margin_print.html>
7Sustainable Gardening. “Liriope”. Perennials. Sustainable Gardening. (Jul 14, 2014) <http://www.sustainable-gardening.com/plants/perennials/liriope>
8The United States National Arboretum. “Crape Myrtle FAQ 2”. October 14, 2004. The United States National Arboretum. (Jul 14, 2014) <http://www.usna.usda.gov/Gardens/faqs/crapemyrtlefaq2.html>
Lab 3: Microbiology and Identifying Bacteria with DNA Sequences
Nicole Bonan
TA: Alyssa Pedersen
Lab Section: D01
July 7, 2014
Introduction
Prokaryotes represent a variety of organisms. These organisms do not have well-organized, membrane-bound organelles, and their genetic material is not enclosed inside a nuclear membrane. Prokaryotes can be grouped into two domains: the Domain Archaea and the Domain Bacteria1. Most Archaea species live in extreme environments, such as in volcanic springs2 and deep-sea hydrothermal vents, and most use chemical energy to create nutrients6. Bacteria represent a wide variety of organisms; the bacteria can be separated into two groups based on the structure of their cell wall3. Bacteria that have a thick layer of peptidoglycan covering their cell walls are considered to be gram positive: these bacteria will stained blue after being washed with crystal violet1. Bacteria that have a much thinner layer of peptidoglycan covering their cell walls are considered to be gram negative: these bacteria will stain pink after being washed with safranin, but they will not retain any color after being washed with crystal violet4. Other types of bacteria that exist include proteobacteria, chlamydiae, spirochetes, actinobacteria, firmicutes, and cyanobacteria1.
There were two purposes of this experiment. The first was to observe the morphological differences between bacteria and their colonies on the agar plates versus the tetracycline plates using a wet mount preparation and gram staining. The second purpose was to set up a polymerase chain reaction (PCR) for each of three bacteria, two from the agar plates and one from the tetracycline plates, so that the DNA of those bacteria can be sequenced in the next lab if there is a PCR product for any of the bacteria. The hypothesis for this experiment was that if samples of the Hay infusion culture had been placed on the plates containing only the agar, then there would be visible growth of bacterial colonies on the plates, and if samples of the culture were placed on the plates containing both agar and tetracycline, then there would not be any observable growth of bacterial colonies, unless tetracycline-resistant bacteria was in the sample. It was not believed that archaea would grow on the plates, as archaea exist mainly in extreme environments, as discussed above. Since both the transect that the soil samples were taken from and the bio lab that the plates were incubated in were not extreme environments, it was unlikely that archaea would have grown in the plates.
In the following report, the methods used, results, data, and interpretation of the results of the experiment will be discussed.
Materials and Methods
First, the four agar and four tetracycline plates were observed by eye. Notes were taken on the number of colonies on each plate, the appearance of the colonies, and the morphological differences between the colonies on the agar and tetracycline plates.
Next, separate wet mounts of one bacteria colony from each of two agar plates and one tetracycline plate were prepared and observed under a microscope. The plates from which the colonies were observed were the 10-3 dilution on the agar plate, the 10-9 dilution on the agar plate, and the 10-3 dilution on the tetracycline plate. The wet mount was prepared by first placing a small sample of each bacterial colony on separate slides using a sterile loop. Then, one drop of deionized water was dropped on each sample with a disposable pipette. The solution was then covered with a cover slip.
After that, gram stains of the same colonies were prepared and observed under a microscope. The gram stain was prepared by first using a sterile loop to place a sample of each colony on separate slides, and then dropping one drop of deionized water over the samples using a disposable pipette. A red wax pencil was used to circle the area underneath the sample. After air-drying, the samples on the slides were heat-fixed by using tongs to pass the slide over a Bunsen burner three times. The samples were then covered with crystal violet for one minute, washed with deionized water, covered with Gram's iodine for one minute, washed again with deionized water, and then decolorized with 95% alcohol for 20 seconds. The alcohol was rinsed off with deionized water, and then the samples were covered with safranin stain for 30 seconds before they were rinsed a final time with deionized water. The samples were then blotted dry with a paper towel and observed under a microscope.
Finally, PCR was set up for sequencing of the 16s gene of the colonies of bacteria. A sample of each of the same colonies that were previously observed were placed into separate sterile tubes containing 100µL water and then incubated at 100°C for 10 minutes. The samples were then boiled for 5 minutes at 13,400rpm. Next, 20µL samples of a primer/water mixture were pipetted into each of three tubes containing primer beads using a micropipette. 5µL of the supernatant from each of the bacterial samples were then pipetted, using a micropipette, into one of the three tubes, so that each tube contained a different bacterial supernatant. These three tubes were each labeled with the transect number (Transect 5) from which the bacteria came, the lab section (D01), and the sample of bacteria (either T3 for the tetracycline 10-3 sample, A3 for the agar 10-3sample, or A9 for the agar 10-9 sample). The tubes were then placed in the PCR machine.
Results
The plates without the tetracycline antibiotic had more bacterial colonies than those with the tetracycline. There seemed to be about 2 species of bacteria that were unaffected by the tetracycline; these colonies were much more circular in shape than those on the plates without the tetracycline. There were also more varieties of colonies on the agar plates than the tetracycline plates. It was unclear which species on the plates were fungi, if any; it was assumed that all of the colonies were bacterial.
Three plates in particular were focused on: the agar plate that contained the 10-3 dilution, the agar plate that contained the 10-9 dilution, and the tetracycline plate that contained the 10-3 dilution. The agar plate containing the 10-3 dilution was covered in many different types of bacterial colonies. All of them were small, and most were either white or yellow and irregularly-shaped. One of the yellow, irregularly-shaped colonies was sampled, and a small organism that consisted of tiny black specs with some filaments was observed though a microscope. The organism was about 5µm long. This colony was also gram-stianed, and it was found to be gram negative. The agar plate that contained the 10-9 dilution had two colonies: one was small, white, and circular, and the other was a white, grey, and filamentous lawn that took up most of the plate. The lawn was sampled, and an organism that was roughly rectangular in shape and had what appeared to be an antenna was observed. The organism had what appeared to be a sponge-like consistency, was a black-gold-dark brown color, and was about 12.5µm across. The lawn was also gram-stained, and was found to be gram positive. The tetracycline plate that contained the 10-3 dilution had four medium-sized bacterial colonies. The colony that was sampled way yellow-orange, circular, and umbonate in elevation. The organism observed in this colony was a donut-shaped bacterium that was 5µm in diameter. The colony was then gram stained, and was found to be gram negative.
Tables and Graphs
Table 1: 100-fold Serial Dilutions Results

Figure 1: Image of Colony on 10-3 Dilution on Agar Plate

Figure 2: Image of Colony on 10-9 Dilution on Agar Plate
Figure 1: Image of Colony on 10-3 Dilution on Agar and Tetracycline Plate
Table 2: Bacteria Characterization

Discussion
Bacteria are a domain of prokaryotic organism. They can be separated into two groups based on the amount of peptidoglycan in their cell wall2. Bacteria that have a thick layer of peptidoglycan covering their cell walls are considered to be gram positive, and they will stain blue after being washed with crystal violet1. Bacteria that have a much thinner layer of peptidoglycan covering their cell walls are considered to be gram negative, and they will stain pink after being washed with safranin. Gram negative bacteria will not retain any color after being washed with crystal violet4.
The purpose of this experiment was to observe the morphological differences between bacteria on the agar plates versus the tetracycline plates and to set up a polymerase chain reaction (PCR) for each of three bacteria, two from the agar plates and one from the tetracycline plates. The hypothesis for this experiment was that if samples of the Hay infusion culture had been placed on the plates containing only the agar, then there would be visible growth of bacterial colonies on the plates, and if samples of the culture were placed on the plates containing both agar and tetracycline, then there would not be any observable growth of bacterial colonies, unless tetracycline-resistant bacteria was in the sample. The results of this experiment were that there was less bacterial growth on the plates containing the tetracycline.
The data did support the hypothesis in this experiment. The highest number of bacterial colonies per mL of solution on the tetracycline plates was 10,000,000 colonies/mL, which was still much lower than the lowest number for the agar plates, 80,000,000 colonies/mL solution. Because the number of bacteria on the tetracycline plates were so much lower than that for the agar plates, it is indicated that only a select few of the bacteria could grow in the presence of tetracycline. Thus, the bacteria could only grow on the tetracycline plates if they were tetracycline-resistant.
The mechanism of action for tetracycline is that it prevents bacteria from synthesizing proteins. The tetracycline does this by first entering the cell by either passive diffusion or an energy-dependent active transport5. It then prevents the attachment of aminoacyl-tRNA to the ribosomal acceptor (A) site. The types of bacteria that are sensitive to tetracycline include many gram-positive and gram-negative bacteria, chlamydiae, mycoplasmas, and rickettsiae3. In this lab, the tetracycline worked to reduce the total number of bacteria that grew on the plates, indicating that many of the bacteria in the soil of Transect 5 were not resistant to the antibiotic.
The appearance or smell of the plates might change from week to week, as different bacteria dominate over others, or as bacteria evolve in the plates. Some bacteria may have stronger odors than others. Also, as the bacteria evolve, the colors, shapes, or sizes of the colonies might change depending on which bacteria are most present or how the bacteria have evolved.
Of course, there were sources of error in this experiment. One source of error was that even though the agar and tetracycline plates were placed side-by-side to incubate, the placement of the agar plates might slightly more hospitable to bacterial growth than the tetracycline plates. Then, the result that there was less growth on the tetracycline plates could have been due not just to the antibiotic properties of tetracycline, but also to the environment in which the bacteria were incubated. This error could have been minimized by running multiple trials of this incubation and comparing the results. Another source of error was that not every colony, especially in the agar 10-3 plate, was able to be counted, as there were so many. Instead, the number of colonies was estimated. Thus, the number of colonies/mL of solution was more of an estimate for plates with many colonies instead of an exact number, which made it more difficult to precisely compare bacterial growth among the plates. This error could have been minimized by spending more time counting all of the colonies. A final source or error was that when the red wax pencil was used to circle the stains on the microscope slides, not all of the pencil seemed to wash off after going through the gram staining wash. Thus, the coloration of some of the organisms after the gram staining may have been affected, causing some organisms to be misidentified as gram negative. This error could have been fixed by using a different medium to circle the stains.
The results of this experiment could be applied to study antibiotic resistance in bacteria. Antibiotic resistance has been becoming more and more of an issue in modern medicine, and ways to prevent bacteria from becoming resistant must be found. The bacteria that grow on the tetracycline plates could be studied to see how these bacteria have evolved to become resistant to the antibiotic. If certain genes in the bacteria are linked to this resistance, a medicine could be created that targets those genes to kill off the bacteria.
References
1Bentley; Walters-Conte; Zeller. 2014. Bio 210 Lab Manual. AU Campus Store: Washington, DC. 11-14.
2Black, Betty L.; Grinder, Tim. “Prokaryotes: Single-Celled Organisms”. Bio 183: Introductory Biology 2. North Carolina State University, Raleigh, NC. (July 9, 2014) http://www.ncsu.edu/project/bio183de/Black/prokaryote/prokaryote1.html
3Chopra, Ian; Roberts, Marilyn. “Tetracycline Antibiotics: Mode of Action, Applications, Molecular Biology, and Epidemiology of Bacterial Resistance”. Tetracycline Antibiotics: Mode of Action, Applications, Molecular Biology, and Epidemiology of Bacterial Resistance. National Center for Biotechnology Information. (July 7, 2014) http://www.ncbi.nlm.nih.gov/pmc/articles/PMC99026/
4Kaiser, Gary E. “Lab 6: Gram Stain and Capsule Stain”. Bio 141 Lab Manual. March 2012. The Community College of Baltimore County. (July 9, 2014) http://faculty.ccbcmd.edu/courses/bio141/labmanua/lab6/lab6.html
5May, D Byron. “Tetracylclines”. Tetracyclines. November 8, 2013. UpToDate. (July 7, 2014) www.uptodate.com/contents/tetracyclines
6National Science Foundation. “How Can Organisms Live Without Sunlight?”. Earth and Environmental Science. National Science Foundation. (July 9, 2014) http://www.nsf.gov/news/overviews/earth-environ/earth_q04.jsp
Lab 2: Identifying Algae and Protists
Nicole Bonan
TA: Alyssa Pedersen
Lab Section: D01
July 2, 2014
Introduction
There are millions of different species on Earth 6, which can ultimately be grouped into either prokaryotes or eukaryotes2. Prokaryotes are simple, unicellular organisms that do not have a nucleus or many organelles4, and they are surrounded by a plasma membrane5. They can be grouped into either the Domain Bacteria, which includes proteobacteria, chlamydias, spirochetes, gram positives, and cyanobacteria, or the Domain Archaea, which includes the euryarchaeota and crenarchaeota. Eukaryotes are more complex; these organisms can be multi or unicellular, and their cells have membrane-bound nuclei and more organelles than prokaryotes. Eukaryotes can be grouped into either algae, which photosynthesize, or protists, which consume nutrients instead of photosynthesizing1.
Dichotomous keys can be used to help identify different organisms. These keys consist of a series of two morphological choices about an organism that is being observed, which, once answered, will allow a person to determine the identity of the organism1.
The purpose of this experiment was to use a dichotomous key and a microscope in order to identify four organisms in the Hay infusion culture created in the previous lab. A serial dilution was then carried out in order to create samples of the culture that would be incubated in separate petri dishes of agar and tetracycline. It was hypothesized that if organisms existed near the top of the Hay infusion culture, then they would be able to photosynthesize, and that if organisms existed near the bottom of the culture, then they would be protists. In the following report, the methods used, results, data, and interpretation of the results of the experiment will be discussed.
Materials and Methods
First, a sample of the Hay infusion culture was taken from near the top of the culture using a disposable pipette. A wet mount was created using a drop of the culture sample, a drop of Protoslo, a cover slip, and a slide. The slide was placed under a microscope, and two organisms in the sample were observed and identified using a dichotomous key. The same procedure was then carried out using a drop of the Hay infusion culture taken from near the bottom of the culture.
Next, serial dilutions of the Hay infusion culture were made after swirling the culture to mix up all of the organisms in it. The first serial dilution was 10-2, which was created by pipetting 100µL of the culture to a test tube containing 100mL sterile broth. The next serial dilution was 10-4, which was created by pipetting 100µL of the 10-2 dilution into a separate test tube of 100mL of sterile broth. The third serial dilution was 10-6, which was created by pipetting 100µL of the 10-4 dilution to a separate test tube containing 100mL of sterile broth. The final dilution, 10-8, was created by pipetting 100µL of the 10-6 dilution into a separate test tube containing 100mL of sterile broth. A 100µL micropipette was used for all of the pipetting in the serial dilutions. A diagram of the serial dilutions is shown in Figure 1 below.
Figure 1: Diagram of Serial Dilutions of Hay Infusion Culture

A sample of each of the serial dilutions were then plated onto agar plates. 100µL of each serial dilution were pipetted, using a 100µL micropipette, onto separate agar plates and spread across the agar using a sterile glass rod. Then, separate 100µL samples of each dilution were pipetted onto separate agar plates that contained tetracycline and were spread across the agar using a sterile glass rod. All of the plates were covered, labeled with the initials of the lab members, and set on a windowsill to incubate at room temperature until the next lab. The tetracycline plates were also labeled with a "T" to distinguish them from the agar plates.
Results
After having incubated since the previous lab, the Hay infusion culture appeared to be about the same opaqueness as lemonade. There was sediment and plant matter at the bottom of the liquid, while the top of the liquid seemed relatively free of this type of matter. The liquid was a light brown color, and the matter at the bottom was very dark brown. The culture had an odor of algae and mildew.
Two organisms were identified from the top of the culture and from the bottom of the culture for a total of four identified organisms. The two organisms identified from the top of the culture were paramecium and amoeba. The paramecium was colorless and was the shape of an elongated oval. It had two vacuoles, a micro and macronucleus, and also had cilia surrounding its outer covering. The paramecium was 50µm long and was a protist. The amoeba had an irregular shape and was mostly colorless, except for the brown-green coloring that surrounded most of its numerous organelles. The amoeba also had a contractile vacuole that was constantly expelling water from the organism. The amoeba was 25µm in length and was a protist. The two organisms that were identified near the bottom of the culture in the sediment and plant matter were chlamydomonas and colpidium. Two chlamydomonas were observed in the same area; both were unicellular, colorless, and roughly cube-shaped. Both also had one pair of flagella, which were used to propel the organism in circular motions. The chlamydomonas were about 50µm in diameter each and were prokaryotes in the Domain Bacteria. Two colpidium were also observed near each other. Both were unicellular, colorless, and oval-shaped. Each organism was motile and had about six organelles. One colpidium was more motile than the other colpidium; this more motile organism tended to bounce around the other organism. At one point, the more motile colpidium seemed to engulf and then regurgitate the other. Both organisms were about 20µm in length and were protists.
Tables and Graphs
Figure 2: Image of Hay Infusion Culture

Table 1: Characteristics of Identified Organisms in Hay Infusion Culture

Figure 3: Illustration of Paramecium

Figure 4: Illustration of Amoeba

Figure 5: Illustration of Two Chlamydomonas

Figure 6: Illustration of Two Colpidium

Discussion
The millions of different species on Earth 6 can be grouped into either prokaryotes or eukaryotes2. Prokaryotes are simple, unicellular organisms that do not have a nucleus or many organelles4, and they are surrounded by a plasma membrane5. Eukaryotes are more complex; they can be multi or unicellular, and their cells have membrane-bound nuclei and more organelles than prokaryotes.1. Dichotomous keys can be used to help identify different organisms. These keys consist of a series of two morphological choices about an organism that is being observed, which, once answered, will allow a person to determine the identity of the organism1.
The purpose of this experiment was to identify four organisms in the Hay infusion culture prepared from Transect 5 soil at American University. The two organisms identified from the top of the culture were paramecium and amoeba; the two organisms identified from the bottom of the culture were chlamydomonas and colpidium. The hypothesis of the experiment was that if organisms existed near the top of the culture, then they would be able to photosynthesize, and if organisms existed near the bottom of the culture, then they would be protists. This hypothesis was made because it was believed that organisms near the top of the culture would have more access to light and would thus be able to photosynthesize, while those at the bottom of the culture would have limited access to light but would be able to obtain nutrients from plant matter. However, the data from the experiment did not support this hypothesis. Both organisms that were taken from the top of the culture and also the colpidium, taken from the bottom of the culture, did not photosynthesize; in fact, they were protists. The chlamydomonas, taken from the bottom of the culture, could photosynthesize. One possible explanation for why the data did not support the hypothesis is that the Hay infusion culture did not incubate long enough for a clear division between photosynthesizing organisms and protists to develop. Another possible explanation is that because there was so much plant matter in the culture, most organisms could obtain nutrients from the plant matter instead of photosynthesizing.
While there did not seem to be clear differences between the organisms observed from near the plant matter and those far away from it, there are possible reasons for why these organisms could have differed under certain circumstances. Organisms near the plant matter most likely would not have gotten much light, but they would be surrounded by nutrient-rich plant matter. Thus, these organisms would most likely not photosynthesize, but they would consume the nutrients available from the plant matter. At the top of the Hay infusion culture, which was far away from the plant matter, there was more light but fewer nutrients from the plant. Thus, the organisms living in this part of the culture would likely photosynthesize rather than obtaining nutrients from plant matter, as the plant matter would have been more scarce than the sunlight.
If the Hay infusion culture had been allowed to incubate for two months, many changes might have occurred to the culture's ecosystem. As time went on, many of the nutrients in the plant matter would likely have been consumed by the organisms in the culture, so this resource would become scarce. As a result, a selective pressure would arise in that protists that had previously relied on the nutrients from plant matter would have to find other sources of nourishment. These protists might evolve into a species that could photosynthesize, as light would likely be more abundant than the plant matter, or they might evolve to be able to consume other microorganisms in the culture.
According to Freeman, Quillin, and Allison's Biological Science, Fifth Edition, most organisms share five fundamental characteristics: they take in and use energy, they are made of cells, they process and respond to information from their environment, they are able to replicate, and their populations evolve 4. The colpidium that was observed from the Hay infusion culture met all of these requirements. The colpidium took in and used energy in order to propel itself through its liquid environment. The organism was unicellular. The organism also processed and responded to information from its environment, as it was able to change direction whenever it bounced into something in its environment. While the colpidium was not directly observed to replicate, it is known that colpidium do replicate. Finally, while the colpidium population was not directly observed to evolve, it is known that its population will evolve over time if its environment changes; for example, if other organisms are introduced that take in the same types of nutrients as colpidium, the colpidium can begin to specialize in its nutrient intake so that the two organisms can coexist 3.
Of course, there were sources of error in this experiment. One source of error was that the Hay infusion culture was moved across the lab in order for samples of it to be taken; during its transportation, some of the plant matter and organisms may have gotten mixed up in the culture, causing some organisms that would normally only exist at the bottom of the culture to be near the top of the culture and vice-versa. A way that this error could have been prevented would have been to take samples from the culture without moving the culture. Another source of error was lack of experience among lab members in identifying microorganisms. While lab members were diligent in determining the identity of organisms, the lab members may have misidentified certain organisms. This error could have been minimized by consulting with other, more experienced lab members in order to confirm the identity of the observed organisms.
The results of this experiment could be applied to future experiments in order to further study the relationship between microorganisms in an ecosystem. For example, the populations of the paramecium, amoeba, colpidium, and chlamydomonas could be studied in order to determine how the populations evolve over time in order to adapt to changing ecological pressures, such as availability of resources. These results could also be applied to the real world in order to study how bacteria become immune to antibiotics and what can be done to overcome this issue. For example, the population of chlamydomonas, a type of bacteria, could be studied to see how the population evolves when faced with an antibiotic. If the chlamydomonas evolves so that it is antibiotic-resistant, changes in certain phenotypes of the organism could be studied to determine whether those phenotypes are linked to the organism's immunity to antibiotics. Then, ways to use that link to prevent future generations of the bacteria from becoming immune to antibacterials could be studied.
References
1Bentley; Walters-Conte; Zeller. 2014. Bio 210 Lab Manual. AU Campus Store: Washington, DC. 11-14.
2Brooker, Robert J. et. al. 2011. Biology: Second Edition.McGrawHill: New York, NY. G-26.
3DeLong, John P.; Vasseur, David A. "Coexistence via Resource Partitioning Fails to Generate an Increase in Community Function". Coexistence via Resource Partitioning Fails to Generate an Increase in Community Function. January 10, 2012. PLOS One. (July 7, 2014) <http://www.plosone.org/article/info%3Adoi%2F10.1371%2Fjournal.pone.0030081>
4Freeman, Scott, et. al. 2014. Biological Science: Fifth Edition. Pearson: Boston. 2; G:29.
5Gregory, Michael. “Prokaryotes”. Biology 2 (Bio 102). State University of New York: Clinton Community College. (July 7, 2014) <http://faculty.clintoncc.suny.edu/faculty/michael.gregory/files/bio%20102/bio%20102%20lectures/prokaryotes/prokaryo.htm>
6Sweetlove, L. 2011. Number of Species on Earth Tagged at 1.7 Million. Nature: International Weekly Journal of Science. 10:1038. (July 7, 2014) <http://www.nature.com/news/2011/110823/full/news.2011.498.html>
Lab 1: Biological Life at AU
Nicole Bonan
TA: Alyssa Pedersen
Lab Section: D01
June 30, 2014
Introduction
Every organism in an ecosystem has its own niche, or an environment that provides all the specific requirements needed for the organism to survive4. The study of how the organisms in an ecosystem interact with other organisms and with their environments can be described by the field of ecology1. Ecosystems include all of the abiotic, or nonliving, and biotic, or living, factors in a specific area2. Ecosystems can be broken down into communities, which are collections of species. These communities can be further broken down into populations, which consists of all of the same type of species that lives in a specific area. Populations are made up of individuals, which are each single organism1.
Over time, populations can evolve through the process of natural selection. Three things that cause natural selection to occur are variability within species, heritability of higher fitness within species, and differing abilities among individuals in a species to survive and pass on their genes to their offspring1. Populations are constantly evolving as individuals adapt to selective pressures in their environment, such as changing sources of food or climate change3.
The objective of this lab was to observe the characteristics of a niche in a transect of the American University ecosystem, Transect 5, and to create a Hay infusion culture from the soil in the transect. In the following report, the methods, results, data, and interpretation of the results of the experiment will be discussed.
Materials and Methods
First, a transect of about 20m x 20m at American University was observed. The area was noted as "Transect 5". Pictures of the transect were taken and notes about the abiotic and biotic components of the transect were written. Next, a sample of the soil was taken in a conical tube. 10g of this soil sample were then added to 0.1g dried milk and 500mL Deer Park water in a plastic jar in order to make a Hay infusion culture. The jar was labeled as "Transect 5 TJ NB".
Results
The area that was observed, Transect 5, was a garden near the entrance to AU's campus. The transect was surrounded by paved sidewalks and was situated in a gully between two roads and a dorm building. The transect was hilly and had many biotic and abiotic components, most of which were landscaped and not naturally-occurring. Most of the biotic components were plants, and most of the abiotic components were stones.
Tables and Graphs
Table 1: Biotic and Abiotic Components of Transect 5
| Biotic Components | Abiotic Components |
|---|---|
| Birds | Rocks and Stones |
| Gnats | Clay, mud, and mulch |
| Bees | Benches |
| Ferns | Stone pathway |
| Spots of Mosses | Drainage ditch |
| Liriope | |
| Trees | |
| Junipers | |
| Ants | |
| Clovers | |
| Plants |
The above table includes all of the biotic and abiotic components of Transect 5 that were recorded. The biotic factors are listed on the left and the abiotic factors are listed on the right.
Figure 1: Aerial View of Transect 5

Figure 2: Transect 5, Image 1

Figure 3: Transect 5, Image 2

Figure 4: Transect 5, Image 3

Figure 5: Transect 5, Image 4

Discussion
Every organism in an ecosystem has its own niche, or an environment that provides all the specific requirements needed for the organism to survive4. Organisms with similar genetic makeups can be grouped into species, and collections of the same species in a given area can be classified as a population1. Populations can evolve over time through the process of natural selection, as individuals adapt to selective pressures in their environment3.
The purpose of this experiment was to observe a transect (Transect 5) American University in order to learn about the types of biotic and abiotic factors in the transect, how they interact with each other, and how these interactions affect their niches. The result of this experiment was that many different abiotic and biotic components were observed in Transect 5 at American University. Most of the biotic components were plants, while most of the abiotic components were stones. The transect was landscaped and not naturally-occurring.
Sources of error existed in this experiment. One source of error was that the transect was only observed at one point on one day rather than multiple times over a longer period of time. Thus, observations about the transect only reflected that one point in time, so some outliers may have existed in the observations (for example, there may not normally be a bird in the transect, but as there was a bird in the transect at the time of observation, the bird was noted as one of the biotic factors in the transect). A way to overcome this error would have been to observe the transect multiple times over a longer period of time. Another source of error was that not every abiotic and biotic component was noted. A way to fix this source of error would have been to spend more time observing the transect and precisely identifying everything in it. A final source of error was that a soil sample was taken in only one small area of the transect, so it may not have accurately represented the majority of the soil and microorganisms in the transect. A way to overcome this error would have been to have taken multiple soil samples in the transect and compared them.
There were many implications of the data that was observed in Transect 5. One implication was that humans had shaped the land in order to suit their needs, and from there, an ecosystem was developed. For example, the drainage ditch that ran through the transect existed because humans needed a drainage system to conduct water away from roads during storms. The area around that drainage system was then landscaped in order to look appealing to humans. The landscaping included plants and trees, which helped to create an ecosystem for birds and insects in the area. Another implication of the data was that Transect 5 had very nutrient-rich soil in the areas where plants and trees were growing. These species were leafy and healthy, which indicated that they were getting the nutrients and water needed to sustain themselves. A final observation of this experiment was that the transect was very clean and organized, in that plants were planted in specific areas and there were few weeds that seemed to be growing randomly throughout the transect. The implication of this observation was that the niches of many species within the ecosystem was controlled by humans; humans decided where plants would be planted, and they worked to get rid of unwanted weeds.
The results of this experiment could be used by others to observe the difference between natural and artificially-created ecosystems. Organisms and their niches in each type of ecosystem could be compared. This data could be used to determine the role that the organisms play in each ecosystem and how those roles differ between naturally-occurring and manmade ecosystems. The differing contributions of organisms to their ecosystems could be used to help determine the health of the overall ecosystem, and whether a manmade ecosystem can be as healthy as a naturally-occurring one. Another use for the results of this experiment could be to help better design gardens so that the niches that organisms occupy within the gardens more closely match the niches that they would occupy in a naturally-occurring ecosystem. In this way, more "green" gardens could be designed that feature more native plants and species to the area in which the garden is planted.
References
1Bentley; Walters-Conte; Zeller. 2014. Bio 210 Lab Manual. AU Campus Store: Washington, DC. 4; 7.
2Freeman, Scott, et. al. 2014. Biological Science: Fifth Edition. Pearson: Boston. G:11.
3Rivera-Guzman, Dr. Javier. (July 3, 2014). Evolutionary Processes and Speciation. Biology 210 Summer Session 2014 Lecture. Lecture conducted from American University, Washington, DC.
4Merriam-Webster, Incorporated. "Niche". Merriam-Webster Online Dictionary. 2014. Encyclopedia Britannica. (July 7, 2014) <http://www.merriam-webster.com/dictionary/niche>